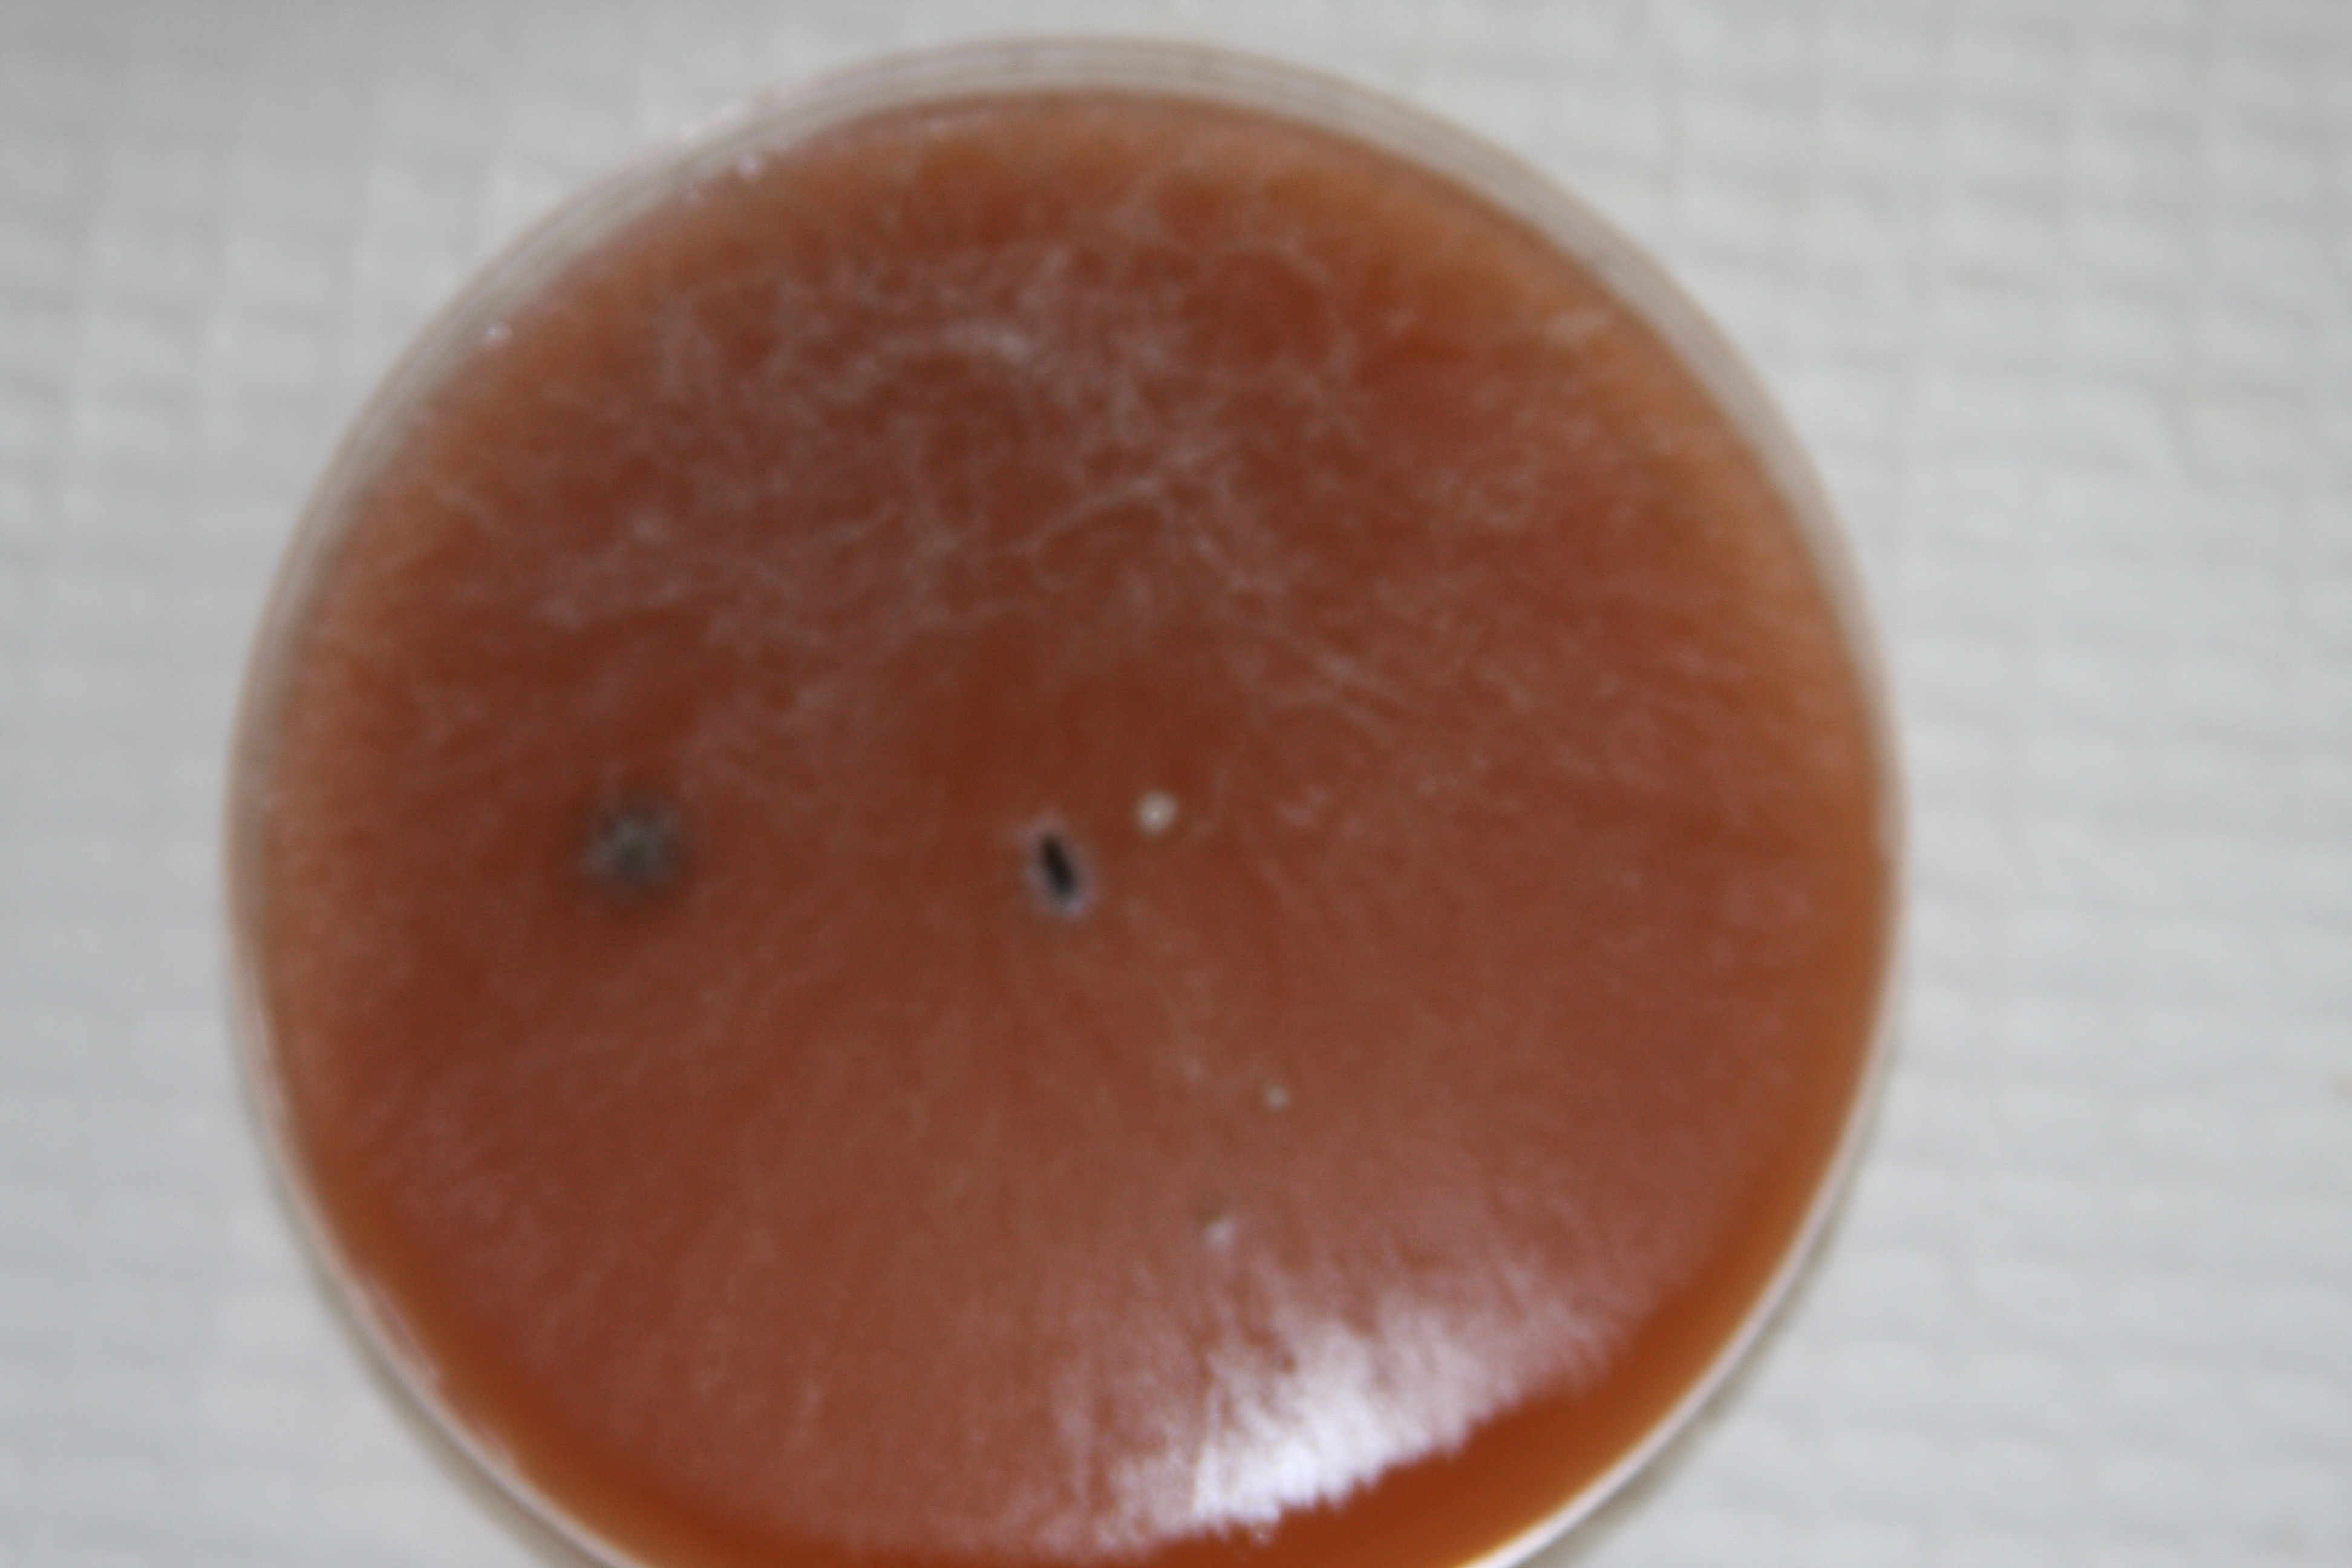

Summer 2010 saw Ian’s involvement increase at Shoals, taking on the responsibility of enhancing research diversity and activities. As such, he spent a total of 10 weeks on the island in the summer, where he conducted several studies, including: 1) an investigation into the impacts of Hyphantria (fall webworm) feces on marine and freshwater bacterial communities around the island; 2) an investigation of limiting factors of Microcystis in the Crystal Lake, which was a proposed source of drinking water on the island; 3) a temporal study of bacterioplankton communities in freshwater pools around the island; and 4) a study of the impact of island location on early microbial colonization. These studies were focused primarily on freshwater bacterioplankton, which were readily accessible on foot from the lab facilities. In addition to the experiments run on the island, Ian served as mentor to a research intern in field science (RIFS), Dani Neuharth-Keusch, who conducted a study comparing separation distance of freshwater pools with the cross-infectivity of aquatic bacteriophage between pools. While out on the island, Ian also collected fecal matter from a variety of Appledore Island wildlife for Ruth Ley (gut microbiome analysis, Microbiology), including a seal that took up residence on a floating dock near the labs.

Publications from this Expedition:
Hewson I, Gitlin SA, Brown JM, Doud DF (2011) “Nucleopolyhedrovirus detection and distribution in terrestrial, freshwater, and marine habitats of Appledore Island” Microbial Ecology 62(1):48-57
